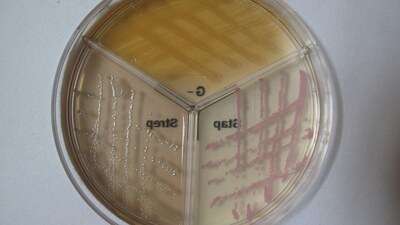
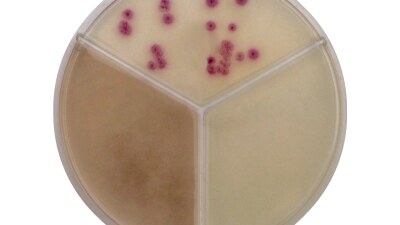
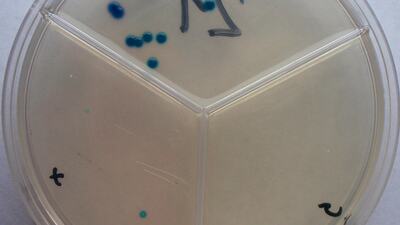
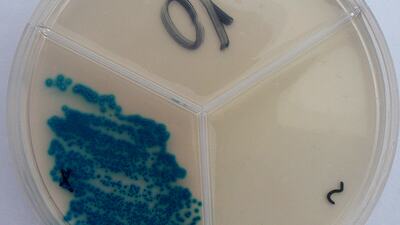
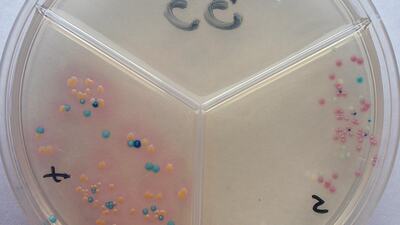

Pure Milk Test
Die Mastitisdiagnose auf dem Bauernhof mit dem PM-Test ist eine schnelle und sehr effektive Lösung für die korrekte Diagnose und dank dieser gezielten Behandlung von Krankheitserregern der Brustdrüsen bei Milchkühen.
Sehr genaue Diagnose eines bestimmten Erregers der Mastitis und Beginn einer gezielten Behandlung innerhalb von 24 Stunden.
Reduzieren Sie die Aufnahme von Antibiotika um zehn Prozent.
Rationalisierung des Einsatzes von Antibiotika im Sinne einer gezielten Behandlung eines bestimmten Wirkstoffs anstelle eines hohen Verbrauchs von Breitbandantibiotika "blind".
Deutliche Verringerung des Befallsrisikos von Nutztieren mit gefährlichen multiresistenten Bakterien.
Der Reinmilchtest ist ein ideales Instrument, um strengere Vorschriften für den Einsatz von Antibiotika in der Milchviehhaltung gemäß der neuen europäischen Gesetzgebung einzuhalten, die seit dem 28. Januar 2022 verbindlich ist.
Der Reinmilchtest kann bequem und einfach direkt in der Umgebung eines Milchviehbetriebs angewendet werden. Im Diagnose-Kit finden Sie alles, was Sie zum Entnehmen und Testen einer Milchprobe benötigen. Desinfektionsmittelabstrich, Einwegröhrchen, sterile Schlaufe zum Aufbringen der Milchprobe und dreiteilige Petrischale mit speziellen chromogenen Agars.